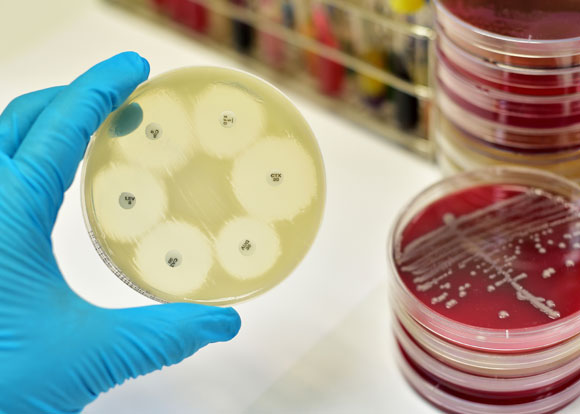
אלח דם הוא גורם המוות המוביל אצל מאושפזים בבתי חולים. צלחות פטרי עם חיידקים | צילום: Shutterstock

הדברים שמפחידים אותנו אינם בהכרח אלה שמסכנים את חיינו באמת. אירועים דרמטיים, כמו אסונות המוניים, זוכים לחשיפה הרבה יותר גדולה מגורמי המוות היומיומיים הפשוטים. מהדורות החדשות, וגם הקולנוע, מעדיפים תמיד משברים ואירועים בלתי צפויים, ומחזקים כך את הפחדים הקיומיים שנטעה בנו האבולוציה מפני הנמר האורב לנו בסבך. ניתוח מהדורות החדשות בארצות הברית מראה כי אירועי טרור, רציחות והתאבדויות מקבלים סיקור תקשורתי נרחב, אף על פי שהם אחראים לשיעור קטן מאוד ממקרי המוות.
החיפושים באינטרנט מלמדים לא מעט על גורמי המוות שמפחידים את רוב האנשים ניתוח מגמות חיפוש באמצעות Google trends מלמד כי מחלות הסרטן זוכות למקום מרכזי מאוד, ובצדק רב, אך אחריהן נמצא תאונות דרכים ואלצהיימר, שאינם בהכרח גורמי תמותה מובילים ובכל זאת אנחנו מפחדים מהם מאוד.

מה הורג את הבנות? גורמי התמותה של נקבות בישראל ב-2016, באחוזים מתוך כלל מקרי המוות | מקור: משרד הבריאות
כדי למצוא מהם הדברים שבאמת מביאים למותנו יש לחפש את הדו”חות התקופתיים שמוציאות רשויות הבריאות באופן שגרתי. מעבר לסיפוק סקרנותנו, הנתונים האלה חשובים גם לבדיקת היעילות של המערכת הרפואית, ומסייעים לקבוע באילו פעולות הנוגעות לבריאות הציבור יש לנקוט – למשל בדיקות סקר נחוצות שיכולות להציל חיים ולמנוע אשפוזים יקרים.
את הדו”ח המעודכן ביותר העוסק בסיבות המוות הנפוצות בישראל פרסם משרד הבריאות ביולי 2019 והוא מסכם את הנתונים מהשנים 2016-2000. באופן לא מפתיע, למעלה ממחצית הנפטרים היו מעל גיל 75, ומספר הנפטרים עלה בהדרגה עם הגיל אחרי גיל 4. הנתונים שלפיהם קבענו את סיבות המוות המובילות נכונים לשנת 2016.

מה הורג את הבנים? גורמי התמותה של זכרים בישראל ב-2016, באחוזים מתוך כלל מקרי המוות | מקור: משרד הבריאות
1. סרטן
שיעור התמותה מכלל הגברים: 26 אחוז (138.4 פטירות למאה אלף אנשים)
שיעור התמותה מכלל הנשים: 25 אחוז (107.5 פטירות למאה אלף אנשים)
סרטן הוא השם הכולל של קבוצת מחלות גדולה שיכולה להופיע בכל איבר או רקמה בגוף. המכנה המשותף לכל המחלות הוא שינוי בתאים שגורם להם להתחלק בלי בקרה. עם התפתחות הגידול, התאים הסרטניים עלולים לפלוש לרקמות נוסף וליצור גרורות, שאחראיות לרבים ממקרי המוות מהמחלה.
סרטן, על סוגיו השונים, היה בשנת 2016 סיבת המוות המובילה בישראל, בקרב גברים ונשים גם יחד. על פי ארגון הבריאות העולמי, סרטן הוא סיבת המוות השנייה בעולם, וההערכה היא כי אחת מכל שש פטירות ברחבי העולם היא תוצאה של גידול ממאיר. ישראל מדורגת 50 בעולם בשיעור התחלואה בסרטן, יחסית לגודל האוכלוסייה.
אף על פי שיש מרכיב גנטי ברבים מסוגי הסרטן, יש ראיות רבות לכך שהתחלואה בסרטן קשורה קשר הדוק לאורח חיים, ושליש ממקרי המוות כתוצאה מסרטן נובעים מגורמי סיכון כגון השמנת יתר, צריכה נמוכה של פירות וירקות, חוסר בפעילות גופנית, עישון טבק וצריכת אלכוהול. על פי ארגון הבריאות העולמי, טבק הוא גורם הסיכון העיקרי לסרטן, ואחראי לכ-22 אחוז ממקרי המוות מהמחלה.
סוגי הסרטן הנפוצים בעולם ובישראל הם סרטן הריאה, סרטן השד, סרטן המעי הגס והחלחולת, סרטן הערמונית וסרטן הקיבה, שיעורי התמותה הגבוהים ביותר הם מסרטן הריאות, סרטן המעי הגס, סרטן הקיבה, סרטן הכבד וסרטן השד.
2. מחלות לב
שיעור התמותה מכלל הגברים: 16 אחוז (86 פטירות למאה אלף אנשים)
שיעור התמותה מכלל הנשים: 15 אחוז (61.2 פטירות למאה אלף אנשים)
מחלות לב הן קבוצה של פתולוגיות בלב ובכלי הדם הסמוכים לו. הן כוללות בין השאר פגמים במסתמי הלב, הפרעות בקצב הלב, דלקות בשריר הלב, אי ספיקת לב וכמובן מחלת לב כלילית, שאחראית לרוב התחלואה והתמותה ממחלות לב.
מחלת לב כלילית (או איסכמית) נגרמת מהצטברות של משקעים על דופן העורקים הכליליים, המזינים את הלב עצמו. בעקבות ההצטברות הזאת, העורקים נהיים צרים יותר ופחות דם מגיע ללב. אצל חלק מהחולים, הסימן הראשון למחלה יהיה אוטם בשריר הלב (התקף לב) הנובע מחסימה מלאה של העורקים ובעקבותיה עצירה של אספקת הדם ללב. במקרים אחרים יהיו סימנים מוקדמים בדמות כאבים בחזה, שנקראים “אנגינה פקטוריס”.
גורמי הסיכון למחלת לב כלילית כוללים גורמים תורשתיים וגורמים התנהגותיים כגון יתר לחץ דם, רמות גבוהות של טריגליצרידים וכולסטרול בדם, סוכרת, עישון, צריכת אלכוהול, חוסר בפעילות גופנית והשמנת יתר.
על פי אגודת הלב האמריקאית, מחלת לב כלילית היא גורם המוות המוביל בעולם, אך ברוב המדינות (כולל ישראל) שיעורי התמותה ממנה ירדו בשנים האחרונות. עם זאת, מומחי האגודה צופים האטה בקצב הירידה הזה, עקב מגמה עולמית של עלייה בחלק מגורמי הסיכון, כגון יתר לחץ דם והשמנת יתר. התמותה ממחלות אלה נמוכה מאוד מתחת לגיל 24, ועולה משמעותית אחרי גיל 45. בשנת 2016, שיעור התמותה בארץ ממחלות לב עמד על 80.1 למאה אלף איש. מדובר בשיעור תמותה נמוך במיוחד, ומבין מדינות ה-OECD, רק בצרפת התמותה נמוכה יותר.

שיעורי התמותה ממחלות לב יורדים בשנים האחרונות, אך הירידה צפויה להתמתן. מחלת לב | איור: Shutterstock
3. מחלות כלי דם במוח (שבץ מוחי)
שיעור התמותה מכלל הנשים: 6 אחוזים (22.7 פטירות למאה אלף אנשים)
שיעור התמותה מכלל הגברים: 5 אחוזים (26.3 פטירות למאה אלף אנשים)
שבץ מוחי נגרם בדרך כלל (כחמש שישיות מכלל החולים) מהיצרות של כלי דם במוח או מחסימה מלאה שלו, תופעה שמכונה שבץ איסכמי. שאר מקרים השבץ נובעים מקרע בכלי דם במוח, שמוביל לדימום (שבץ דימומי).
גורם הסיכון העיקרי לשבץ מוחי הוא יתר לחץ דם, ולפי הערכות היה אפשר להציל ארבעה מכל עשרה אנשים שמתו משבץ מוחי אילו היו מטפלים מבעוד מועד בלחץ הדם הגבוה שלהם. גורמי סיכון נוספים הם תזונה לא מאוזנת ועשירה במלח, מחלות לב, סוכרת ורמות שומנים גבוהות בדם. אולם מעל כל הסיבות הללו נמצא העישון: 40 אחוז מהאנשים מתחת לגיל 65 שנפטרו משבץ היו מעשנים.
סיכויי התמותה משבץ תלויים בסיבה שגרמה לו. סיכויי ההישרדות הגבוהים ביותר כשהשבץ קורה עקב הצרת כלי דם במוח. חסימה מלאה של כלי דם, למשל עקב קריש דם, מפחיתה את סיכויי ההחלמה של החולה, ואילו מקרע בכלי דם במוח הכי פחות סביר לשרוד.
גם במדינות מפותחות, עם טיפולים מתקדמים וזמינים, כ-60 אחוז מהאנשים שיחוו אירוע מוחי ימותו או יסבלו מנכות ארוכת טווח בעקבותיו. על כן יש לפגיעות כאלה השלכות חברתיות וכלכליות רחבות היקף, בעיקר בגילאים מתקדמים. כ-15 מיליון איש בעולם לוקים מדי שנה משבץ. שליש מהם ימותו בעקבותיו, ושליש נוסף יסבלו מנכות קבועה. שיעור הפטירות משבץ מוחי בישראל עמד בשנת 2016 על 28.2 למאה אלף איש: הוא בין הנמוכים במדינות ה-OECD ונמצא בשנים האחרונות בירידה.

כ-60 אחוז מהאנשים שיחוו אירוע מוחי ימותו או יסבלו מנכות ארוכת טווח. מיפוי כלי דם במוח | מקור: Shutterstock
4. סוכרת
שיעור התמותה מכלל הגברים: 5 אחוזים (27.5 פטירות למאה אלף אנשים)
שיעור התמותה מכלל הנשים: 5 אחוזים (22.1 פטירות למאה אלף אנשים)
סוכרת היא מחלה כרונית המאופיינת בעלייה בריכוזי הסוכר (גלוקוז) בדם. במצב תקין, הגוף האנושי מגיב לעלייה ברמות הגלוקוז בדם בהפרשה של ההורמון אינסולין, הנחוץ לספיגת הגלוקוז בתאים. אולם לחולי סוכרת יש בעיה בהפרשת האינסולין מהלבלב או בתגובה של התא אליו, ולכן הגלוקוז מצטבר בדם ואינו נכנס לתאים.
הצטברות הסוכר בדם מובילה לנזקים ארוכי טווח ועלולה לפגוע בכלי דם, בכליות, בעיניים ובלב. בסוכרת מסוג 1, שנקראה בעבר “סוכרת נעורים”, הלבלב אינו מפריש מספיק אינסולין. ואילו בסוכרת מסוג 2 התאים מפסיקים להגיב לאינסולין ולכן אינם קולטים לתוכם גלוקוז. כתשעה מכל עשרה חולי סוכרת סובלים מהסוג השני, שמתפתח לאורך שנים רבות ולכן מופיע בדרך כלל בגיל מבוגר. גורמי הסיכון לסוכרת מסוג 2 הם השמנת יתר, דיאטה שאינה מאוזנת וחוסר פעילות גופנית. הקפדה על אורח חיים בריא מסייעת במיתון התסמינים. הרקע לסוכרת מסוג 1 הוא כנראה גנטי בדרך כלל.
בשנת 2016, כ-1.6 מיליון מקרי מוות ברחבי העולם קושרו ישירות לסוכרת, מחציתם מתחת לגיל 70. מעל גיל 45 נצפית עלייה משמעותית בשיעורי התמותה מסוכרת, והיא הופכת להיות אחד מגורמי המוות המובילים. סוכרת היא מחלה נפוצה מאוד בישראל ושיעורי המוות ממנה כאן הוא הגבוה ביותר במדינות ה-OECD. הנתון הזה צריך להדליק נורה אדומה הן בקרב הציבור הרחב והן אצל רשויות הבריאות, שכן סוכרת מסוג 2 היא מחלה שאפשר למנוע במידה רבה באמצעות מעבר לאורח חיים בריא ומאוזן.

סוכרת מסוג 2 היא מחלה שאפשר למנוע במידה רבה באמצעות מעבר לאורח חיים בריא ומאוזן. קוביות סוכר | צילום: Shutterstock
5. אלח דם
שיעור התמותה מכלל הנשים: 5 אחוזים (20.3 פטירות למאה אלף אנשים)
שיעור התמותה מכלל הגברים: 5 אחוזים (26.5 פטירות למאה אלף אנשים)
אלח דם (Sepsis) הוא מצב שמתרחש עקב תגובה קיצונית של הגוף לזיהום חיידקי שפלש לזרם הדם. מדובר במצב חירום רפואי מסכן חיים, שדורש התערבות מיידית. אלח דם יכול לפגוע בכולם, אך יש אוכלוסיות בסיכון גבוה במיוחד, ובכלל זה זקנים, ילדים מתחת לגיל שנה, נשים הרות, אנשים שמערכת החיסון שלהם חלשה (למשל עקב טיפולים כימותרפיים) וכן אנשים שסובלים ממחלות רקע כמו סרטן, מחלות כבד ומחלות כליה.
אף שמרבית המקרים של אלח דם לא מתפרצים בבתי חולים, מחקר שנעשה במרכז לבקרת מחלות (CDC) בארצות הברית מצא כי 72 אחוז מהחולים שנבדקו קיבלו טיפול רפואי כלשהו בשלושים הימים שקדמו להופעת אלח הדם.
אלח דם אינו בין עשרת גורמי המוות העיקריים בארצות הברית, אך הוא גורם המוות המוביל אצל מאושפזים בבתי חולים, שכן רבים מהחולים נזקקים לטיפול רפואי צמוד, והתמותה מאלח דם ממשיכה לעלות. בישראל, משרד הבריאות מנטר את התחלואה באלח הדם בבתי החולים, ובמיוחד במחלקות הטיפול הנמרץ, שכן רבים מהמקרים אפשר למנוע באמצעות פעולות ממוקדות. על פי דיווחי משרד הבריאות, משנת 2012 והלאה חלה ירידה בכמות האשפוזים במחלקות טיפול נמרץ עקב אלח דם, אך עדיין יש מקום לשיפור.
בעוד שאלח דם הוא סיבת המוות החמישית בתפוצתה בישראל, הוא לא נמצא אפילו בין עשר סיבות המוות המובילות בקנדה, ארצות הברית ואירופה. הסבר אפשרי לכך הוא רישום לא מלא בהודעות הפטירה בישראל, כשרופאים מציינים כסיבת הפטירה רק את אלח הדם, בלי להתייחס למצב הרפואי שהוביל להתפתחות המצב מסכם החיים הזה – למשל, סרטן. בשנים 2016-2014 מספר המתים הממוצע מאלח דם בישראל עמד על 24.1 מקרים לשנה למאה אלף בני אדם.
אלח דם הוא גורם המוות המוביל אצל מאושפזים בבתי חולים. צלחות פטרי עם חיידקים | צילום: Shutterstock
6. מחלות כליה
שיעור התמותה, גברים: 4 אחוזים (20.8 פטירות למאה אלף אנשים)
שיעור התמותה, נשים: 3 אחוזים (14.1 פטירות למאה אלף אנשים)
מחלות כליה הן אוסף של פתולוגיות שמובילות להפרעה בפעילות הכליה – איבר שתפקידיו העיקריים הם לסנן את הדם ולווסת את לחץ הדם. בין השאר מדובר בזיהומים בכליה (Nephritis) ובמצבים שפוגעים בצינוריות הכליה ובמערכת הסינון שלה. הנזק יכול להתפתח ממחלה הפוגעת בכליה עצמה (מחלת כליה ראשונית) או ממצב רפואי אחר (מחלת כליה שניונית). למעלה ממחצית ממחלות הכליה הן מחלות שניוניות, שבין הגורמים המובילים להן נמצאים סוכרת ויתר לחץ דם. אנשים הסובלים ממחלות כליה נמצאים בסיכון מוגבר למחלות אחרות, כמו שבץ מוחי או אוטם שריר הלב.
מחלות כליה נמצאות גם בין סיבות המוות המובילות בעולם, ושיעור התמותה מהן נמצא בעלייה. בארצות הברית, מחלות כליה הן גורם המוות התשיעי, ושיעור התמותה הוא 15.5 למאה אלף תושבים. בהשוואה למדינות ה-OECD, ישראל היא המדינה שבה שיעור התמותה ממחלות כליה הוא הגבוה ביותר ועמד בשנת 2015 על 34.5 למאה אלף אחרי תיקנון לגיל. לשם השוואה, שיעור התמותה הממוצע ממחלות כליה במערב אירופה היה 12.8.

למעלה ממחצית מחלות הכליה הן מחלות שניוניות שבין הגורמים להן סוכרת ויתר לחץ דם. טיפול דיאליזה | צילום: Shutterstock
ועוד משהו
גורמי המוות שצוינו כאן רלוונטיים בעיקר מגיל 45 ומעלה. בגיל צעיר יותר סרטן הוא עדיין סיבת המוות המובילה, אך מיד אחריו נמצאים גורמי מוות אלימים כמו רצח, התאבדות ותאונות, וכן מומים מולדים.
בעולם כולו רואים בשנים האחרונות מגמות של ירידה בתמותה ממחלות מידבקות כמו מלריה, שחפת וזיהומי מעיים, לצד עלייה בתמותה ממחלת אלצהיימר ומסוגים אחרים של דמנציה, כנראה עקב שילוב של אבחון משופר ועלייה בתוחלת החיים.
ברוב הפרמטרים, ישראל נמצאת במקום טוב לעומת שאר מדינות ה-OECD. שיעור התמותה הכללי בה נמוך מרוב מדינות הארגון (מקום 19 מתוך 25 מדינות שיש נתונים לגביהן) ורוב גורמי המוות נמצאים בירידה בירידה בעשור האחרון. ועם זאת, העובדה המצערת היא שכל עוד לא מצאנו את הדרך לחיי נצח, כל אחד חייב בסופו של דבר למות ממשהו. שיהיה לנו בהצלחה!


